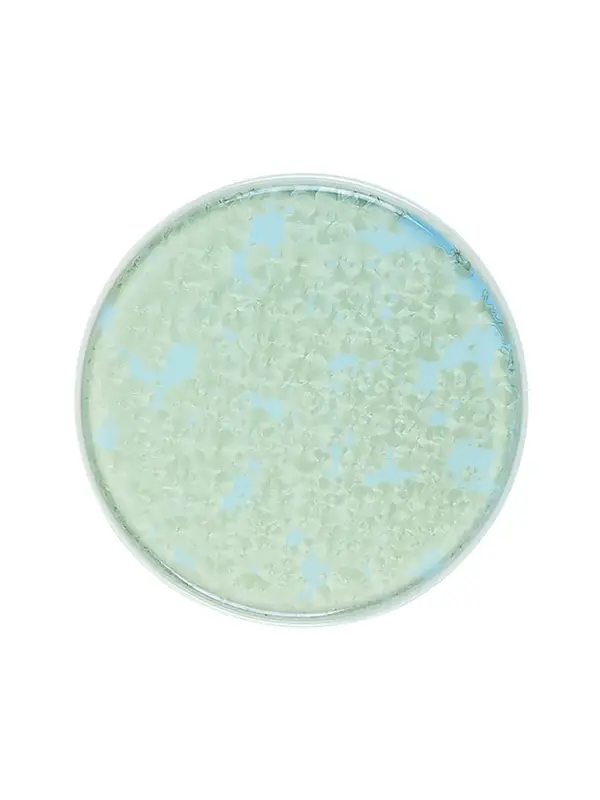
Тарелка с бортом, Royal Charm, Frost, 26 x 1.9 см, зеленая

Тарелка с бортом, Royal Charm, Frost, 26 x 1.9 см, зеленая
Арт. 03015744%
В наличии
| Производитель | Royal Charm |
| Серия |
Frost |
| Страна | Китай |
| Материал | Фарфор |
| Диаметр | 26 см |
| Высота | 1.9 см |
| Цвет | Зеленый |
| Мойка в П/М | Нет |
| Использование в СВЧ | Нет |
| Тип товара | Мелкие столовые тарелки |
| Кратность товара | 1 |
1630 ₽ RUB
-
+





-260x208.webp)